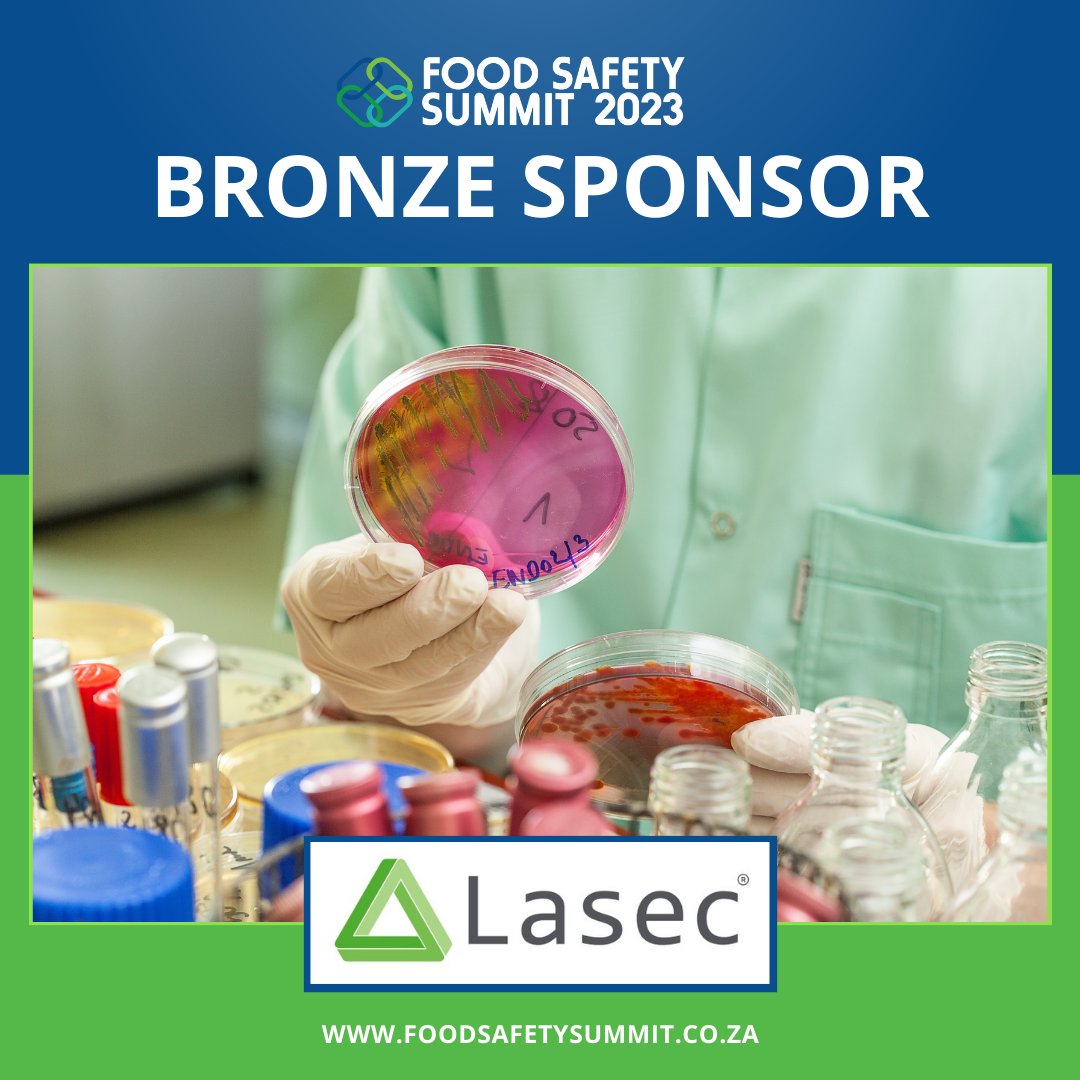
Our bronze sponsor, Lasec® has been supplying quality, dependable solutions, and services to the laboratory and scientific community for over 75 years. Read more here - lasec.com

#foodsafetyculture #foodsafetysystems #fss2023 #foodindustry #foodlaboratory

Anelich Consulting
@anelichconsult1
Owner, Professor Lucia Anelich is one of South Africa’s most well-known food safety and microbiology experts. Accomplished international speaker and author.
ID: 952556002401976320
http://www.anelichconsulting.co.za 14-01-2018 15:00:23
803 Tweet
333 Followers
142 Following






Anelich Consulting welcomes christophe merieux NutriSciences as a sponsor of the Listeria one-day seminar to be held 21 February 2024. Free and online. Register: register.gotowebinar.com/register/18807… ICMSF Jeffrey Mark Farber Leon Gorris @lauraKstrawn Chilled Food Association Dr. Faith Critzer Elna Buys John Oppong-Otoo


Alert! Scammers posing as Standard Bank Fraud department are calling. I received one last night. Smelt a rotten fish based on the questions asked and cut the call. Then phoned actual Standard Bank ZA fraud line and they confirmed it was a scam. Please be vigilant! Wendy Knowler

Listeria seminar 21 Feb 2024 - free and online. Thank you @MerieuxNutrisciences for your sponsorship! #listeria #listeriosis #foodsafety #foodindustry Wendy Knowler African Union SAAFoST Register: register.gotowebinar.com/register/18807… Programme: anelichconsulting.co.za/listeria/